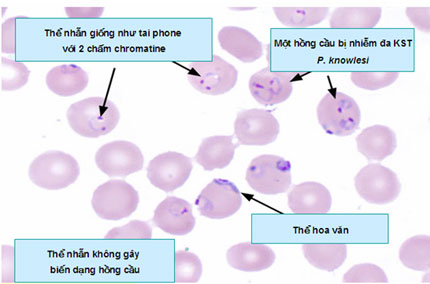

Đặc điểm sinh học và hình thái loài Plasmodium knowlesi
Quan sát các giai đoạn hồng cầu nhiễm KSTSR qua lam nhuộm giêm sa từ các BNSR chỉ nhiễm đơn thuần P. knowlesi đã xác định bằng phương pháp nested PCR trước đó và thẩm định lại (Cox-Singh và cs., 2008; Oon Tek Ng và cs., 2008) trước đó cho thấy KST P. knowlesi ái tính cả loại hồng cầu non lẫn hồng cầu già nên khả năng xâm nhập vào các hồng cầu rất cao với số lượng lớn. Trong chu trình phát triển vô tính, P. knowlesi ở người giống với hình thể P. falciparum. Khi trưởng thành, các thể vô tính cho hình ảnh lại giống P. malariae;
-Thể vô tính giai đoạn sớm/ trẻ giống như loài P. falciparum:
+Thể nhẫn giai đoạn sớm thường giống nhẫn của P. falciparum;
+Không có nhìn thấy hạt Schuffner trong hồng cầu;
+Tư dưỡng non dạng mãnh, hoặc tư dưỡng đang phát triển hình dãi băng, ít biến dạng/ không biến dạng hồng cầu;
+Tư dưỡng thường có một nhân, nhưng ngoại lệ cũng có nhân chấm đôi như hình ảnh tai nghe phone;
+Thường mật độ KST cao, dao động trên một loạt 10 ca bệnh chọn ngẫu nhiên dao động từ 610 – 236.000/ μl máu (Kim Sung Lee và cs., 2009), nguyên sinh chất không đứt đoạn mà liên tục một dải dài;
+Thể tư dưỡng non xuất hiện các hình nhẫn và khó có thể phân biệt với tư dưỡng non P. falciparum, có khi xuất hiện nhiều hơn 1 thể nhẫn trong mỗi hồng cầu, hoặc thể tư dưỡng non dạng mãnh mai, tư dưỡng đang phát triển hình dãi băng, ít biến dạng hoặc không biến dạng hồng cầu, thể tư dưỡng đang tăng trưởng nhân đôi;
+Các tư dưỡng P. knowlesi có thể chấm đôi chromatin dot và cùng lúc có thể tồn tại 2-3 KST trong một hồng cầu và thể phân liệt trưởng thành của P. knowlesi có đến 16 merozoite, so với 12 đối với P. malariae.
-Thể tư dưỡng già/ trưởng thành giống với loài P. malariae
+Thể nhẫn giai đoạn muộn sẽ rất giống loài P. malariae;
+Tư dưỡng trưởng thành có bào tương đậm đặc, không biến dạng, hoặc hình dãi băng/ hay dải khăn quàng dễ nghĩ đến P. malariae;
+Thể phân liệt trưởng thành trong hồng cầu với hình gai ở rìa và, hoặc có một cụm nằm ở trung tâm (8 - 16 tiểu thể hoa cúc), trung tâm có màu vàng – đen đậm (hay chấm Sinton và Mulligan);
+Các thể phân liệt già đã không chiếm hết toàn bộ hồng cầu, hoặc thể phân liệt không làm trương HC, có hình ảnh hoa văn khác biệt;
+Thể tư dưỡng già có mặt ít hơn 1/3 số hồng cầu bị nhiễm và bào tương đậm đặc, không biến dạng hồng cầu; có thể có hình ảnh 10 merozoites sắp xếp đối xứng hơn hay ít hơn quanh một cụm ở giữa;
+Các thể tư dưỡng và phân liệt được nhuộm sắc tố đậm đặc với sắc tố màu nâu, hoặc đậm hoặc màu đen;
+Các hồng cầu nhiễm thấy tư dưỡng già và phân liệt trong lam giọt đặc, chúng không trương phình, các đặc điểm trên tuy riêng nhưng đôi khi tương tự các hồng cầu nhiễm P. malariae điển hình.
-Thể giao bào loài P. knowlesi có điểm đặc biệt
+Thể giao bào tương tự với giao bào của P. malariae, có hình tròn, chiếm hầu hết thể tích hồng cầu;
+Giao bào già hay cho hình ảnh sắc tố phân tán rải rác, không đều.
Tỷ lệ nhìn thấy giao bào chỉ 1.2-2.8% số ca ghi nhận được trong số 10 ca được chọn ngẫu nhiên. Các giao bào trưởng thành đặc trưng hình cầu chiếm gần trọn hồng cầu, chấm chromatin đặc chắc và hạt pigment màu đen nâu, rải rác không đều.
Các giao bào trẻ chiếm 2/3 hồng cầu nhiễm và khó phân biệt với tư dưỡng trưởng thành. Bao tương của macrogametocytebiểu hiện hơi xanh với các chấm chromatin màu hồng đặc chắc nằm ở ngoại vi của ký sinh trùng.
Ngược lại, bào tương của microgametocytes nhuộm màu hồng tím với các khối chromatin lớn, đậm đen nằm vị trí khác nhau.
Các hạt nhỏ pigment trên cả giao bào đực và cái nhìn thấy phân bố không đều, song cácmacrogametocyte có kết cụm chấm pigment sốt rét nâu đen. Các hồng cầu nhiễm nhìn chung không lớn, dù cho một số giao bào nhìn thấy hơi nhỏ hơn hồng cầu không nhiễm. Do đặc điểm hình thái học đa dạng của P. knowlesi như vậy khi tương đồng với P. falciparum khi tương đồng với P. malariae khiến cho khâu chẩn đoán chuẩn vàng giêm sa gặp nhiều khó khăn và đôi khi phân vân trong ghi nhận kết quả chẩn đoán, ngay cả các chuyên gia về kính hiển vi KSTSR cũng có một tỷ lệ nhầm lẫn dưới 10%, nếu không kết hợp với triệu chứng lâm sàng và thẩm định lại bằng kỹ thuật sinh học phân tử (PCR và giải trình tự gen)
|
| Hình 1.Một số hình ảnh thể nhẫn và tư dưỡng non đặc biệt của P. knowlesi |
 |
| Hình 2. Hình thái học các giai đoạn KSTSR P. knowlesi trong hồng cầu ở trên bệnh nhân A và B: tư dưỡng non, thể nhẫn với chấm đôi chromatin, hoặc 2 thể tư dưỡng, C: tư dưỡng già thể dãi băng và tư dưỡng già thể hình cầu. D và E: thể phân liệt trong hồng cầu. E, F, G, H: thể giao bào. |
Hình ảnh trên lam giọt mỏng cố định với cồn tuyệt đối methanol trong 10 giây và để khô ở nhiệt độ phòng trước khi nhuộm.
Lam giọt mỏng và dày sẽ nhuộm giêm sa 3% và 10% trong nước đệm Gurr, pH 7.2 trong 30 phút.
 |
| Hình 3. Một số hình ảnh của thể tư dưỡng P. knowlesi dưới kính hiển vi của BNSR do P. knowlesi tại biên giới Malaysia, Thái Lan-Myanmar |
| Bảng 1. Sự tương đồng về hình thái giữa KSTSR của khỉ và người |
Loài Plasmodium spp. từ khỉ | Loài Plasmodium spp. tương đồng | Vùng phân bố địa lý | Tại châu Á | P. coatney | P. falciparum | Malaysia, Philippines | P. cynomolgi | P. vivax | Ấn Độ, Indonesia, Malaysia, Sri Lanka, Đài Loan | P. eylesi | P. vivax | Malaysia | P. fieldi | P. ovale | Malaysia | P. fragile | P. falciparum | Ấn Độ, Sri Lanka | P. hylobati | P. vivax | Indonesia | P.inui | P. malaria | Ấn Độ. Indonesia, Malaysia, Philippine, Sri Lanka, Đài Loan | P. jeffrey | P. vivax | Indonesia, malaysia | P. knowlesi | P. malariae, P. falciparum | Trung Quốc, Indonesia, Malaysia, Philippines, singapore, Thái Lan, Đài Loan | P.pitheci | P. vivax | Malaysia | P. simiovale | P.ovale | Sri Lanka | P. silvaticum | P. vivax | Malaysia | P. youngi | P. vivax | Malaysia | Tại Nam Mỹ | P. brasillanum | P. malariae | Brazil, colombia, Mexico, Panama, Peru, Venezuela | P. simium | P. vivax | Brazil |
|
Chu kỳ phát triển của ký sinh trùng sốt rét P. knowlesi
Như các loài Plasmodium spp gây bệnh ở người đã biết, ký sinh trùng P. knowlesi hoàn thành giai đoạn vô tính trong máu là 24 giờ, nên xuất hiện mật độ KSTSR rất cao chỉ trong một thời gian ngắn 24 giờ. Điều này sẽ gợi ý một tiềm năng có thể dẫn đến diễn tiến bệnh nghiêm trọng, thậm chí gây ra SRAT với nhiều biến chứng và tử vong nếu không được điều trị thuốc đặc hiệu. Như các loài Plasmodium khác, thì loài P. knowlesi cũng phát triển theo 2 giai đoạn trong muỗi và cơ thể người.
Hạn chế của phương pháp chẩn đoán dựa vào kính hiển vi
Xét nghiệm ký sinh trùng sốt rét với lam máu nhuộm Giêm sa soi bằng phương pháp kính hiển vi được xem là tiêu chuẩn vàng (gold standard) để phát hiện loài và đếm mật độ ký sinh trùng sốt rét (KSTSR) và có thể thiết lập chẩn đoán ở mật độ ký sinh trùng > 50 ký sinh trùng/μl máu ngoại vi.
Hình thái khác nhau của hồng cầu khi bị ký sinh bởi loài KSTSR có thể quan sát rõ ràng ở các lam máu giọt mỏng, điều này cho phép xác định hầu hết chính xác các loài ký sinh trùng. Tuy nhiên, việc áp dụng đơn thuần phương pháp soi kính hiển vi thì không thể phân biệt chính xác loài P. knowlesi với P. falciparum, P. malariae và P. vivax.
Thể tự dưỡng non của P. knowlesi có thể bị chẩn đoán nhầm lẫn với của P. falciparum do chúng có các đặc điểm tương tự nhau như khi có mặt hai nhân trong một hồng cầu (double chromatin dots), hồng cầu nhiễm có kích thước lớn và các hình thức khác. Thể tự dưỡng già và trưởng thành, thể phân liệt (schizonts) và giao bào trưởng thành của P. knowlesi thường không thể phân biệt với những người nhiễm P. malariae.
Sự hiện diện nhiều tế bào chất di động theo kiểu a-míp của thể tự dưỡng già ở loài P. knowlesi có thể là đặc tính chỉ sự khác biệt với các trường hợp nhiễm P. malariae nhưng đặc điểm này thỉnh thoảng chỉ được quan sát thấy và khó để xác định được ngay cả với một người soi kính hiển vi được đào tạo bài bản. "Thể tự dưỡng hình dãi băng là một đặc tính điển hình của ký sinh trùng sốt rét P. malariae cũng thấy ở các trường hợp nhiễm P. knowlesi (!).
Trong một nỗ lực đánh giá hiệu quả của kính hiển vi trong việc chẩn đoán sốt rét do P. knowlesi, tác giả Barber và cộng sự thông qua nghiên cứu đã chứng minh rằng phương pháp kính hiển vi có thể chẩn đoán nhầm P. knowlesi là P. vivax và P. falciparum và ngược lại.
Các tác giả đã quan sát thấy rằng chỉ có 72% phản ứng chuỗi polymerase (PCR) khẳng định P. knowlesi có thể được xác định một cách chính xác trên kính hiển vi và 30% của P. vivax bị chẩn đoán nhầm là P. malariae/ hoặc P. knowlesi.
Các test phát hiện kháng nguyên ký sinh trùng sốt rét chưa đầy đủ
Xét nghiệm miễn dịch sắc ký chẩn đoán nhanh hay gọi chung là test chẩn đoán nhanh (Rapid diagnostic immunochromatographic tests - RDTs) phát hiện kháng nguyên ký sinh trùng sốt rét đang được sử dụng rộng rãi và phổ biến ở hầu hết các nước lưu hành bệnh sốt rét, để thay thế cho việc áp dụng kinh hiển vi (đặc biệt nơi ít khi đối mặt với bệnh nhân sốt rét hoặc nơi có hệ thống kính hiển vi yếu và kém chất lượng) để phân biệt sự khác nhau giữa các loài Plasmodium spp nhiễm ở người.
Sốt rét do loài P. vivax và P. falciparum chiếm ưu thế trong cơ cấu KSTSR; do vậy, gần như tất cả các test RDTs được thiết kế để phát hiện một trong hai hoặc cả hai kháng nguyên của hai loài này trong một bộ kít duy nhất để phát hiện hai loài ký sinh trùng sốt rét này ở người. Các RDTs với kháng thể đơn dòng chống lại kháng nguyên đặc hiệu cho P. vivax (P. vivax specific lactate dehydrogenase, pvLDH) chỉ để xác định loài ký sinh trùng sốt rét P. vivax, trong khi những kháng thể chống lại kháng nguyên đặc hiệu HRP2_histidine rich protein-2 hoặc kháng nguyên pLDH đặc hiệu loài P. falciparum (P. falciparum specific parasite Lactate DeHydrogenase, hay pfLDH) đặc biệt để phát hiện loài P. falciparum.
Ngoài ra, một số RDTs cũng phát hiện nhưng không phân biệt các kháng nguyên các loài Plasmodium spp khác bằng cách sử dụng kháng thể đơn dòng chống lại các chỉ thị sốt rét phối hợp như lactate dehydrogenase pan-Plasmodium (pLDH) hoặc Plasmodium aldolase (PALD).
Việc đưa các test RDTs vào chẩn đoán sốt rét ở người là một cuộc cánh mạng lớn, do chúng có những ưu điểm như nhanh chóng, dễ sử dụng, linh hoạt ở các điểm xét nghiệm chăm sóc sức khỏe và chi phí hiệu quả. Các test RDTs có khả năng phát hiện ở ngưỡng mà mật độ ký sinh trùng lớn hơn 100 ký sinh trùng/μl máu ở cả bốn loài Plasmodium phổ biến (P. vivax, P. falciparum, P. ovale và P. malariae).
Cho đến nay, test RDTs đặc hiệu để phát hiện loài P. knowlesi không có trên thị trường và các phiên bản hiện có của RDTs được tìm thấy đều thực hiện sai khi được sử dụng tại các khu vực lưu hành loài P. knowlesi. Độ nhạy của chỉ điểm sốt rét phối hợp PALD, đã được tìm thấy ở mức thấp nhất trong khi phát hiện kháng nguyên P. knowlesi khi so sánh với việc phát hiện kháng nguyên P. falciparum và P. vivax.
Độ nhạy chung của PALD để phát hiện P. knowlesi được báo cáo là thấp với tỷ lệ 23%. Hơn nữa, độ nhạy của PALD đã được quan sát thấy chỉ có 45%, ngay cả với mật độ ký sinh trùng cao hơn 10.000 ký sinh trùng/μl, điều này làm cho nó không thích hợp để phát hiện các trường hợp chỉ nhiễm trùng P. knowlesi. Việc thực hiện không đầy đủ các PALD như một dấu hiệu chẩn đoán có thể là do biến đổi di truyền gen mã hóa aldolase, sản xuất các phân tử không đồng nhất của việc thay đổi mối quan hệ để các kháng thể đơn dòng được sử dụng trong các hệ thống phát hiện.
Độ nhạy của chỉ điểm sốt rét phối hợp pLDH khác trong việc phát hiện P. knowlesi được ước tính là thấp tới 25% ở mật độ ký sinh trùng dưới 1.000 ký sinh trùng/μl và độ nhạy này tăng lên 97% khi mật độ ký sinh trùng hơn 1.000 ký sinh trùng/μl. Thực hiện một nghiên cứu thú vị là mối tương quan trực tiếp với cường độ của dãi băng màu sắc ký pLDH với mật độ ký sinh trùng P. knowlesi.
Đối với những quan sát này, nó đã cho thấy pLDH chỉ có thể được sử dụng như một chỉ điểm thay thế để dự đoán nguy cơ mắc bệnh nghiêm trọng, nhưng không phải để phát hiện bệnh sốt rét do P. knowlesi không biến chứng sớm.
Các trường hợp nhiễm loài P. knowlesi cũng đặt ra một trở ngại lớn trong việc chẩn đoán chính xác hai loài P. vivax và P. falciparum khi sử dụng các RDTs. Các biểu hiện protein và đặc tính của P. knowlesi lactate dehydrogenase (PkLDH) đã được chứng minh có 96,8% tương đồng với pvLDH và trên 90% tương đồng với PfLDH. Tương tự, kháng nguyên này tiếp tục chịu trách nhiệm cho các phản ứng chéo được quan sát thấy ở loài P. vivax và P. falciparum, các RDTs đặc hiệu được thiết kế để phát hiện các pLDH đặc hiệu ký sinh trùng.
Do các phản ứng chéo ở các RDTs, nên sốt rét do P. knowlesi có thể đã bị chẩn đoán sai là sốt rét do P. vivax hoặc sốt rét do P. falciparum, điều này dẫn đến điều trị không thích hợp và đánh giá sai về dữ liệu dịch tễ học cũng như cơ cấu ký sinh trùng.
McCutchan và cộng sự cho thấy phản ứng chéo của các kháng nguyên P. knowlesi với kháng thể đơn dòng của pvLDH và pfLDH có thể thực sự được sử dụng để phát hiện P. knowlesi ở các khu vực lưu hành (?). Tuy nhiên, việc giải thích có thể là sai lầm do bản chất không đặc hiệu và nhiễm phối hợp có thể được bỏ qua.
Trong tình hình hiện nay, có nhiều kháng nguyên được nghiên cứu cho thấy rằng phù hợp để xác định loài P. knowlesi cụ thể đang được tiếp tục nghiên cứu, đánh giá. Sử dụng công nghệ tái tổ hợp axit deoxyribonucleic (ADN), tác giả Singh và cộng sự trong khi nghiên cứu đã phát triển 34 kDa pkLDH và đã đề xuất vai trò của nó trong RDTs để chẩn đoán P. knowlesi cụ thể.
Do phản ứng chéo được thể hiện giữa các kháng nguyên pLDH của các loài Plasmodium khác nhau, nên khả năng sử dụng của nó là có vấn đề. Trong bối cảnh này, mục tiêu kháng nguyên mới với sự gia tăng độ đặc hiệu phân biệt giữa các loài đang được đánh giá. Một số mục tiêu nghiên cứu bao gồm các protein bề mặt P. knowlesi merozoite (pkMSP1), protein bề mặt P. knowlesi merozoite-142 (pkMSP-142), P. knowlesi 1-Cys peroxiredoxin và protein bề mặt P. knowlesi chứa đựng phạm vi thrombospondin thay đổi lặp lại.
Tuy nhiên, những phân tử này cũng không phải không có phản ứng giữa các loài và mục tiêu kháng nguyên lý tưởng là chưa được xác định.
Công cụ phát hiện chẩn đoán phân tử đối với P. knowlesi
Do các khiếm khuyết hay nhược điểm lớn trong phương pháp kính hiển vi và các xét nghiệm phát hiện kháng nguyên (RDTs), các phương pháp phân tử hiện nay không phải là lựa chọn an toàn duy nhất cho chẩn đoán xác định bệnh sốt rét do P. knowlesi.
Trong thực tế, phát hiện sốt rét do P. knowlesi ở người chỉ có thể được thực hiện bằng kỹ thuật phân tử. 18S tiểu đơn vị nhỏ rRNA (ssu-rRNA), gen mã hóa protein bề mặt xung quanh sporozoite, gen nhân mã hóa protease cysteine và gen mã hóa Cytochrome b là một trong số những mục tiêu nghiên cứu và khai thác bởi các xét nghiệm phát hiện phân tử.
Trong số các mục tiêu nói trên, các biến đổi di truyền ở 18S ssu-rRNA là những mục tiêu nghiên cứu tập trung nhiều nhất và được sử dụng rộng rãi để phân biệt các loài cụ thể trong các loài KSTSR Plasmodium khác nhau. Các xét nghiệm này có thể phát hiện DNA ký sinh trùng chiết xuất từ các mẫu như máu toàn phần với chất chống đông, vết máu khô trên giấy thấm và các lam máu đã nhuộm sau khi phân tích bằng kính hiển vi, thậm chí các mẫu máu trên que thử chẩn đoán nhanh.
Các xét nghiệm mới hơn cũng có một tính năng bổ sung để phát hiện các gen như β-hemoglobin hoặc β-actin. Điều này đáp ứng kiểm soát dương tính bên trong cơ thể để đánh giá thành công của quy trình tách chiết DNA và loại trừ sự hiện diện của chất ức chế DNA polymerase.
Xét nghiệm phân tử lần đầu tiên được triển khai để phát hiện loài P. knowlesi là PCR đa mồi lồng kinh điển (conventional Nested multiplex PCR) nhằm mục tiêu gen 18S ssu-rRNA được phát triển bởi tác giả Singh và cộng sự. Kỹ thuật này, gen mục tiêu đầu tiên được khuếch đại bằng cách sử dụng các mồi cụ thể (rPLU1 và rPLU5) và do các bản sao được đưa ra chu kỳ thứ hai của khuếch đại bằng cách sử dụng mồi đặc hiệu loài để xác định các loài; P. falciparum (rFAL1 và rFAL2), P. vivax (rVIV1 và rVIV2), P. ovale (rOVA1 và rOVA4), P. malariae (rMAL1 và rMAL2) và P. knowlesi (Pmk8 và Pmkr9). Sau đó, nó đã được quan sát thấy rằng cặp mồi Pmk8 và Pmkr9 cũng khuếch đại một phần DNA của P. vivax, do vậy xác định sai là loài P. knowlesi.
Phản ứng chéo ngẫu nhiên đã được quy cho sự khuếch đại giả DNA của P. vivax bởi các đoạn mồi đặc hiệu P. knowlesi. Để khắc phục nhược điểm này, Imwong và cộng sự đề nghị sử dụng mồi PkF1150 và PkR15560 đặc hiệu hơn ở vòng khuếch đại thứ hai thay vì các cặp mồi sai Pmk8 và Pmkr9. Ngoài ra, Nguyen Van Hong và các cộng sự báo cáo rằng tính đặc hiệu của PCR lồng (nested PCR) có thể được tăng lên bằng cách sử dụng cặp mồi PkR4 để khuếch đại mỗi DNA của P. knowlesi ở vòng thứ ba riêng biệt và không cùng với các loài khác khuếch đại ở vòng thứ hai.
Các xét nghiệm sinh học phân tử PCR lồng thông thường rất nhạy và có khả năng phát hiện P. knowlesi ngay cả khi mật độ ký sinh trùng dưới 10 ký sinh trùng/μl. Mặc dù, kỹ thuật PCR lồng được xem là "tiêu chuẩn vàng phân tử - molecular gold standard" trong chẩn đoán bệnh sốt rét nhưng nó có nhiều nhược điểm khác nhau.
Vì kỹ thuật liên quan đến 5 - 6 phản ứng PCR riêng biệt để phát hiện 5 loài Plasmodium hiện gây bệnh ở người, nó đòi hỏi một số lượng lớn các chất phản ứng và xảy ra nhiễm chéo cũng như kỹ thuật này cồng kềnh, tốn nhiều thời gian và đào tạo nhân lực chuyên môn cao.
Có những thuận lợi như chẩn đoán nhanh, định lượng trực tiếp phân tích khuếch đại và lây nhiễm chéo rất nhỏ, Real time multiplex PCR dựa vào các phương pháp đã thay thế những các phương pháp thông thường. Divis và cộng sự báo cáo xét nghiệm TaqMan ban đầu khuếch đại DNA của tất cả 5 loài Plasmodium ở người bằng cách sử dụng một bộ mồi thông thường, từ đó từng loài được xác định bằng cách sử dụng mẫu dò thủy đặc hiệu loài (species-specific hydrolysis probes).
Mặc dù, các tác giả báo cáo mức độ nhạy và độ đặc hiệu cao ở các trường hợp nhiễm đơn (chỉ nhiễm 1 loài ký sinh trùng sốt rét), họ đề cập đến rằng có thể làm giảm độ nhạy trong việc phát hiện mật độ ký sinh trùng thấp hơn ở các trường hợp nhiễm phối hợp do cạnh tranh cho các đoạn mồi bởi DNA của các loài phong phú hơn.
Trong một nghiên cứu tiếp theo, Shokoples và cộng sự giải quyết vấn đề này với những thay đổi nhỏ trong đoạn mồi và trình tự thăm dò, do đó làm tăng độ nhạy của xét nghiệm real time PCR trong phân biệt các trường hợp nhiễm phối hợp.
Trong xét nghiệm real time PCR được sử dụng bởi Babady và cộng sự, các tác giả phải đối mặt với vấn đề chồng chéo đường cong nóng chảy của P. knowlesi và P. vivax, gây cản trở phân biệt hai loài này.
Để khắc phục điều này, các tác giả nhấn mạnh sự cần thiết của các fluorophores riêng biệt cho thăm dò P. vivax và P. knowlesi hoặc sử dụng mồi đặc hiệu duy nhất cho P. knowlesi.
Các xét nghiệm Real time PCR có độ nhạy cao và có thể phát hiện thậm chí mật ở độ ký sinh trùng rất thấp từ 1-2 ký sinh trùng/μl.
Như vậy, Real time PCR là một trong những kỹ thuật xét nghiệm phân tử tiên tiến nhất để phát hiện P. knowlesi nhiễm phối hợp với các Plasmodium ở người khác. Nó có thể được giới thiệu trong bất kỳ trong phòng thí nghiệm hiện có được trang bị trước đó.
Tuy nhiên, do các loại hóa chất xét nghiệm đắt tiền và chi phí lắp đặt cao nên đây là những hạn chế lớn phải đối mặt khi giới thiệu kỹ thuật xét nghiệm này vào phòng thí nghiệm với những hạn chế về nguồn lực.
Xem xét những hạn chế phải đối mặt bởi PCR lồng kinh điển và các xét nghiệm Real time PCR, Chen và cộng sự đã phát triển một hệ thống đơn giản có tên single-step hexaplex PCR system nhắm đến mục tiêu 18S rRNA-ssu trong 5 loài ký sinh trùng sốt rét Plasmodium ở người.
Độ đặc hiệu cao của các đoạn mồi đặc hiệu loài loại bỏ sự cần thiết cho cách thức PCR lồng.
Với khả năng phát hiện mật độ ký sinh trùng sốt rét ở mật độ 0,25 ký sinh trùng/μl, xét nghiệm này đã được báo cáo là có độ nhạy cao hơn so với bất kỳ xét nghiệm PCR khác hiện đang có sẵn để phát hiện P. knowlesi. Khả năng phân biệt ít nhất hai loài Plasmodium trong các trường hợp nhiễm phối hợp, điều này phản ánh độ đặc hiệu cao của xét nghiệm.
Bỏ qua việc tính đến tốn thời gian cho nhiều vòng khuếch đại ADN như trong PCR đa lồng (Nested multiplex PCR) và sự cần thiết có các thiết bị và hóa chất đắt tiền như kỹ thuật với real time PCR, phương pháp Hexaplex PCR mới này chứng minh áp dụng thực tế nhiều hơn.
Xét nghiệm Hexaplex này được bán trên thị trường như sản phẩm PlasmoNex™ và có thể chạy trên chu trình nhiệt thông thường bởi gel agarose. Tương tự như vậy, Lucchi và cộng sự đã thiết kế một mục tiêu đơn giản duy nhất PCR thông thường đang sử dụng các bộ mồi Pkr140-5 nhắm đến mục tiêu "loài đặc hiệu và trình tự đa bản sao" trong bộ gen DNA của P. knowlesi.
Các tác giả đề nghị mục tiêu mới là rất đặc hiệu đối với P. knowlesi không có phản ứng chéo với bất kỳ các Plasmodium ở người và khỉ.
Các tác giả chỉ ra tiềm năng của xét nghiệm này như một công cụ xác định phân tử đơn giản ở các vùng lưu hành P. knowlesi.
LAMP (Loop mediated isothermal amplification) là một trong những phương pháp phân tử khuếch đại nhanh chóng acid nucleic ở nhiệt độ không đổi.
Kỹ thuật này sở hữu một số lợi thế vốn có trong PCR như nhanh chóng, người sử dụng đào tạo tối thiểu và chi phí lắp đặt thấp hơn vì nó không đòi hỏi chu trình nhiệt đắt tiền.
Hiện nay, có hai phương pháp xét nghiệm LAMP khác nhau đã được phát triển và nghiên cứu độc lập để tiện ích trong việc chẩn đoán bệnh sốt rét do P. knowlesi. Xét nghiệm LAMP được thiết kế bởi Iseki và cộng sự phát hiện gen mã hóa β-tubulin đặc hiệu P. knowlesi bằng cách sử dụng ba bộ mồi, trong khi đó Lau và cộng sự mục tiêu là đỉnh màng gen kháng nguyên-1 của P. knowlesi với 6 mồi. Các xét nghiệm này có khả năng phát hiện mức độ ký sinh trùng rất thấp và được công bố là có độ nhạy hơn 10-100 lần so với các phiên bản PCR có sẵn hiện nay. Do độ nhạy cao, xét nghiệm LAMP có thể được thực hiện trực tiếp trên mẫu máu bỏ qua các cách thức chiết suất phức tạp và tốn nhiều thời gian.
Mặc dù, có nhiều lợi thế rõ ràng nhưng các xét nghiệm LAMP đã thất bại trong việc kích thích sự quan tâm như là một phương thức chẩn đoán chính xác, hiệu quả do sự phổ biến của các hệ thống PCR ưu thích hiện nay.
Khung chẩn đoán cho ký sinh trùng Plasmodium knowlesi ?
Như bệnh sốt rét ở người do 4 loài Plasmodium spp. kinh điển khác, SR do nhiễm P. knowlesi cũng được chẩn đoán dựa vào các phổ triệu chứng lâm sàng và khẳng định thông qua xét nghiệm chuẩn vàng lam máu nhuộm giêm sa và một số kỹ thuật khác (PCR hoặc test nhanh) hỗ trợ.
Chẩn đoán dựa trên biểu hiện lâm sàng
Các triệu chứng lâm sàng bắt đầu sau khoảng 11-12 ngày kể từ khi nhiễm KSTSR, nghĩa là giai đoạn ủ bệnh ngắn nhất so với các loài KSTSR trên người và khỉ đã biết, nên KST có thể phát hiện được trong máu khoảng từ ngày thứ 10 - 13. KSTSR nhân lên trong giai đoạn vô tính (24 giờ) nhanh chóng và mật độ KSTSR vì thế sẽ đạt rất cao chỉ trong thời gian ngắn, thậm chí có thể gây tử vong ngay như đối với P. falciparum.
Như các loài khác gây sốt rét, các triệu chứng của SR do P. knowlesi ở người gồm có nhức đầu, sốt nóng, rét run và vả mồ hôi. Trong một điều tra trên 94 BNSR nhiễm đơn loài P. knowlesi cho thấy bệnh nhân có biểu hiện như các trường hợp sốt rét do các loài Plasmodium spp. khác, gồm rét run,sốt nóng và vả mồ hôi, cơn sốt hàng ngày chiếm 100%, nhức đầu 32%, ho là 18%, nôn mửa 16%, buồn nôn 6%, đại tiện phân lỏng 4%, biểu hiện bệnh từ vừa đến nặng, thậm chí đã có ca bệnh tử vong (Singh và cs., 2004: Coatney và cs., 2003). Loài P. knowlesi không gây SR tái phát vì không có thể ngủ hoặc thể ẩn (dormant / hypnozoite form) trong nhu mô tế bào gan.
Cần nhớ rằng các nghiên cứu từ các nhóm tác giả khác nhau chỉ ra nhiều trường hợp SR do P. knowlesi là không biểu hiện triệu chứng, trong khi phần lớn số ca SRAT và tử vong cũng như sốt rét thường do P. knowlesi ở Malaysia lại có triệu chứng rõ ràng và tương đối điển hình.
Một kinh nghiệm được rút ra bởi một số nhà lâm sàng ở Singapore (O.T. Ng và cs., 2009) có thể đủ gợi ý chẩn đoán ca bệnh SR là do P. knowlesi. Chẳng hạn, trước một ca bệnh, sự đánh giá các biểu hiện lâm sàng bệnh nặng, tiền sử bệnh nhân cóđi du lịch đến vùng Đông Nam Á gần đây, kết hợp chẩn đoán bằng KHV cho hình ảnh nghi nhiễm P. malariae (?) vì nếu P. malariae thì thường biểu hiện hình thái lâm sàng lành tính. Ngoài ra, bất kỳ chẩn đoán SR nào mắc phải ở Đông Nam Á cũng nên cảnh báo hay thận trọng là khả năng có nhiễm P. knowlesi và cần tích cực điều tra bệnh sử cũng như chú trọng chẩn đoán phân tử và điều trị kịp thời, cứu sống bệnh nhân.
Chẩn đoán qua xét nghiệm chuẩn vàng lam máu nhuộm giêm sa
Loài KSTSR P. knowlesi có chu kỳ phát triển trong hồng cầu hay chu kỳ vô tính chỉ 24 giờ, với cấu trúc gen học rất gần với loài P. vivax và qua thực thế xét nghiệm chuẩn vàng lam nhuộm giêm sa cho thấy nhiều đặc điểm hình thái học giống loài P. malariae hoặc/ và loài P. falciparum tùy thuộc giai đoạn phát triển trong máu. Sự xuất hiện P. knowlesi có một số giai đoạn tương tự như P. falciparum hoặc P. malariae và không thể chẩn đoán loại trừ một cách thỏa đáng nếu chỉ dựa vào lam máu (một số hình thể của loài P. knowlesi trên lam máu được trình bày ở trên.
 |
| Hình. Tương đồng các thể KST P. knowlesi với P. falciparum & P. malariae |
Theo Janet và cộng sự (2006) cho biết trong tổng số 960 lam máu của các BNSR nhập viện thì có đến 228 lam bị chẩn đoán nhầm là P. malariae nhưng sau đó các lam máu này phân tích lại với 226 ca được xác định là P. knowlesi chứ không phải loài P. malariae, (bằng phân tích PCR và nested PCR). Do đó, để phân biệt chính xác 2 loài KSTSR này nhất thiết phải sử dụng các kỹ thuật sinh học phân tử hoặc phân tích DNA khác.
Ngay cả các vùng sốt rét ở các đảo và quần đảo của Malaysia và Indonesia, Singapore – nơi có nhiều ca bệnh báo cáo SR do P. knowlesi hiện có rất nhiều kinh nghiệm trong soi kính hiển vi phát hiện P. knowlesi vẫn còn một tỷ lệ sai sót trong số bệnh nhân mà họ ghi nhận trong 5 năm gần đây, đến khi xác định lại bằng kỹ thuật PCR thì kết quả chuyển dịch từ P. falciparum và P. malariae thành P. knowlesi khá nhiều. Do tính dễ nhầm lẫn hình thái học đa dạng của P. knowlesi với P. falciparum và/ hoặc P. malariae trong hồng cầu nhiễm như thế nên vai trò lúc này của xét nghiệm máu nhuộm giêm sa soi kính hiển vi đã giảm đi vai trò “chuẩn vàng” của nó.
Điểm lưu ý là các hồng cầu nhiễm loài này ở tất cả giai đoạn nhìn chung không trương phình, hồng cầu nhiễm bị bóp méo, biến dạng là một đặc điểm hay gặp trong nhiễm trùng ở khỉrhesus nhiễm P. knowlesi, lại hiếm gặp trên nhiễm trùng ở người với P. knowlesi. Không có chấm tương tự như các Schüffner's dot như đã từng thấy trên hồng cầu nhiễm P. vivax. Tuy nhiên, các chấm mờ nhạt như các dot không đều là bằng chứng trong vài hồng cầu nhiễm thể tư dưỡng trưởng thành và phân liệt. Loại chấm trong hồng cầu nhiễm P. knowlesi thường các tác giả gọi là chấm 'Sinton và Mulligan's stippling và như chỉ điểm lưu ý nhiễm trùng trên khỉ rhesus và người.
Theo tác giả Sinton và Mulligan, là những người đầu tiên mô tả các chấm này chỉ phù hợp trên các hồng cầu nhiễm của khỉ giống macaca, khi dùng phương pháp toàn phần của Green để nhuộm. Tương tự như trong nhiễm trùng P. malariae, các hồng cầu nhiễm không trương phình xoắn vặn.
Chẩn đoán bằng test chẩn đoán nhanh(RDTs)
Đối với các vùng KHV không hoặc chưa bao phủ, hoặc nơi đó nhân viên không có kinh nghiệm trong chẩn đoán SR thì việc áp dụng các test chẩn đoán nhanh (Rapid Diagnostic Tests_RDTs) để phát hiện kháng nguyên rất thiết thực và quan trọng, rất tiện lợi cả tại phòng xét nghiệm và điều kiện thực địa. Ngưỡng phát hiện KSTSR bằng test nhanh rất nhỏ, so với độ nhạy với KHV thì cao gấp 5 lần. Một nhược điểm của RDTs là test định tính chứ không phải định lượng, nên không thể xác MĐKSTSR trong máu.
Loại test dùng để hỗ trợ trong chẩn đoán chuẩn vàng giêm sa phải là test vừa phát hiện đặc hiệu loài P. falciparum (kháng nguyên HRP2) ở vạch số 1 và phát hiện kháng nguyên non-falciparum (pLDH) ở vạch số 2.Vì test như thế có phát hiện loại kháng nguyên pLDH khi KSTSR (hoặc P. vivax, hoặc P. malariae, hoặc P. ovale) còn sống thì mới cho kết quả dương tính. Nếu kết quả đọc chỉ xuất hiện vạch 2, kèm theo mật độ KSTSR cao cùng với biểu hiện lâm sàng nặng, các nhà lâm sàng có thể nghĩ đến BNSR này nhiễm loài P. knowlesi, đặc biệt hình ảnh soi giêm sa lại giống như như P. malariae.
Do vậy, các test RDTs có thể hoặc không thể phát hiện ra P. knowlesi vì lệ thuộc vào tính đặc hiệu của test phát hiện.
Hiện tại, các nhà khoa học đang phát triển một loại test có thể phân biệt đặc hiệu từng loài Plasmodium nếu cài đặt trên que thử các pLDH isoenzyme đặc hiệu loài của chúng (McCutchan và cs., 2008; Jaap J. van Hellemond và cs., 2008).
Chẩn đoán sốt rét P. knowlesi dựa vào sinh học phân tử
Các kỹ thuật sinh học phân tử như PCR hoặc nested PCR, Real time-PCR và một số kỹ thuật phân tử khác đang được ứng dụng tại các la bô hiện đại để chẩn đoán và nghiên cứu về các loài KSTSR, các biến thể, tính đa dạng về kháng nguyên, trong đó có phân tích loài P. knowlesi. Các kỹ thuật này vừa giúp chẩn đoán xác định loài, vừa giúp nghiên cứu sâu về dịch tễ học phân tử làm sáng tỏ các khía cạnh khác cho loài KSTSR mới này ở người.
Vì mật độ KSTSR không phải lúc nào cũng tương quan với diễn tiến của bệnh, đặc biệt khi KSTSR kết dính vào thành mạch máu.
Do đó, các công cụ chẩn đoán nhạy hơn là cần thiết để phát hiện KSTSR, đặc biệt khi mật độ ngưỡng rất thấp. Hầu hết các nhà nghiên cứu đã ứng dụng cặp mồi Pmk8 và Pmk9 (Singh B và cs., 2004).
Thử nghiệm này có thể ứng dụng cho nested PCR khi sàng lọc một số lượng lớn mẫu, xác định các trường hợp nghi ngờ hoặc nhầm lẫn trên lam nhuộm giêm sa rằng P. falciparum hoặc P. malariae.
Song, nếu như về mặt hình thái học của P. knowlesi tương đồng với P. falciparum và P. malariae thì về mặt di truyền, P. knowlesi lại có điểm đặc biệt với P. vivax. Gần đây có tác giả cho biết cặp mồi P. knowlesi có “phản ứng chéo” với DNA bộ gen của P. vivax nên khả năng tạo kết quả dương tính giả là có thể, nên cần nghiên cứu cải tiến thêm (Imwong và cs., 2009; E. Sulistyanisih và cs., 2010).
Một số thông số cận lâm sàng khác hỗ trợ chẩn đoán
Ngoài các kết quả của chẩn đoán về mặt lâm sàng, hình thái học dựa vào lam nhuộm giêm sa, xác định DNA dựa vào sinh học phân tử và phát hiện kháng nguyên KST dựa vào test chẩn đoán nhanh thì một số xét nghiệm cận lâm sàng khác cũng được các nhà nghiên cứu đề cập và quan tâm: đó là trị số nồng độ C - reactive protein (CRP) tăng gấp nhiều lần trong máu và có hiện tượng giảm tiểu cầu nặng. Điều tra trên các bệnh nhân biểu hiện SRAT và tử vong do P. knowlesi đều cho số lượng tiểu cầu thấp và thấp hơn so với các trường hợp nhiễm loài Plasmodium spp. khác.
Những nhà nghiên cứu cho rằng có thể sử dụng chỉ số tiểu cầu trong máu thấp để làm yếu tố bổ sung chẩn đoán bệnh sốt rét do P. knowlesi.
Điểm kết
Hiện nay, nhiễm P. knowlesi ở người hình như được ‘giới hạn” tại các nước Đông Nam Á với số lượng lớn các trường hợp mắc được báo cáo ở Malaysia, Myanmar và Thái Lan.
Trong các khu vực lưu hành, kính hiển vi là phương pháp quan trọng trong chẩn đoán ký sinh trùng sốt rét. Phát hiện ký sinh trùng sốt rét trong phòng thí nghiệm hiếm khi bị bỏ lỡ nhưng sự lây nhiễm thường được chẩn đoán sai do nhiều yếu tố khách quan lẫn chủ quan.
Trong hầu hết các trường hợp chẩn đoán sai sốt rét do P. knowlesi là sốt rét do các loài ký sinh trùng sốt rét khác nhưng không gây ra thiệt hại rõ ràng, vì một tỷ lệ lớn các bệnh nhân thường là biểu hiện lâm sàng nhẹ và đáp ứng tốt với các loại thuốc chống sốt rét bằng đường uống.
Tuy nhiên, việc chẩn đoán sai trong các trường hợp bệnh nặng có thể trì hoãn việc điều trị bằng đường thuốc tiêm dẫn đến hậu quả chết người. Vì vậy, sốt rét do P. knowlesi có nguy cơ gấp nhiều lần hơn trong sự phát triển của các biến chứng so với bệnh sốt rét do P. falciparum (nếu chậm trễ trong chẩn đoán), một chẩn đoán chính xác và kịp thời có thể cứu sống được bệnh nhân.
Nhiều nghiên cứu đã chỉ ra rằng, việc sử dụng kính hiển để chẩn đoán ký sinh trùng sốt rét P. knowlesi có nhiều nhầm lẫn, do vậy sự cần thiết phải có phương pháp chẩn đoán tốt hơn để phát hiện các trường hợp nhiễm P. knowlesi. Mặc dù, hiện nay có nhiều kỹ thuật phân tử để chẩn đoán chính xác 5 loài ký sinh trùng sốt rét nhưng việc áp dụng rộng rãi các phương pháp phân tử này thường quy còn nhiều hạn chế do nguồn lực có hạn cũng như thiếu thiết bị chẩn đoán ở các vùng lưu hành. Các test chẩn đoán nhanh (RDTs) có chi phí - hiệu quả, do vậy được sử dụng rộng rãi để chẩn đoán sốt rét, nhưng không có test chẩn đoán nhanh để phát hiện đặc hiệu P. knowlesi. Nghiên cứu biểu hiện gen và protein để xác định kháng nguyên đặc hiệu mục tiêu, điều này có thể dịch chuyển một cách hiệu quả để tạo ra các loại test RDTs phù hợp là sự cần thiết.
Hiện nay, tỷ lệ mắc bệnh sốt rét do P. knowlesi đang gia tăng nhanh chóng tại nhiều quốc gia trong khu vực Đông Nam Á, do vậy các du khách trở về từ các nước có bệnh sốt rét do P. knowlesilưu hành thì nhân viên chăm sóc y tế phải nghĩ đến hoặc chần đặt ra chẩn đoán nghi ngờ nhiễm P. knowlesi. Với sự có mặt của vật chủ động vật phù hợp và các véc tơ tại các địa điểm địa lý tiếp giáp như miền Tây Ấn Độ, các nhân viên y tế ở các vùng này cần phải nhận thức ký sinh sốt rét “thách thức” này và có đủ thận trọng để chẩn đoán kịp thời và cứu lấy tính mạng bệnh nhân.